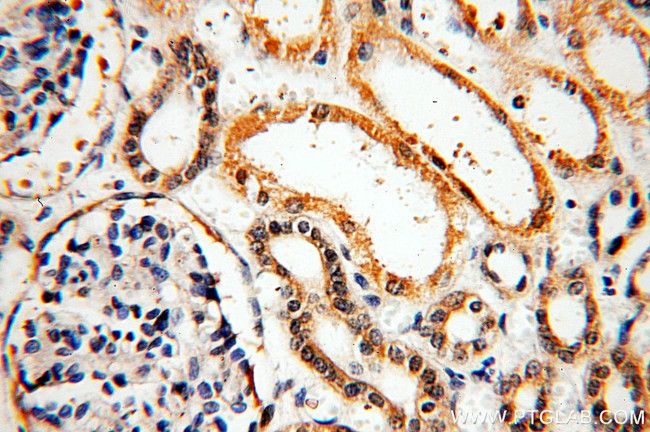
KLHL29 Antibody in Immunohistochemistry (Paraffin) (IHC (P))

Search
Proteintech
KLHL29 Polyclonal Antibody
{{$productOrderCtrl.translations['antibody.pdp.commerceCard.promotion.promotions']}}
{{$productOrderCtrl.translations['antibody.pdp.commerceCard.promotion.viewpromo']}}
{{$productOrderCtrl.translations['antibody.pdp.commerceCard.promotion.promocode']}}: {{promo.promoCode}} {{promo.promoTitle}} {{promo.promoDescription}}. {{$productOrderCtrl.translations['antibody.pdp.commerceCard.promotion.learnmore']}}
产品信息
20162-1-AP
种属反应
宿主/亚型
分类
类型
抗原
偶联物
形式
浓度
规格
纯化类型
保存液
内含物
保存条件
运输条件
产品详细信息
Immunogen sequence: YFKDLIQRS VQDSGQGGRE KLELVLSNLQ ADVLELLLEF VYTGSLVIDS ANAKTLLEAA SKFQFHTFCK VCVSFLEKQL TASNCLGVLA MAEAMQCSEL YHMAKAFALQ IFPEVAAQEE ILSISKDDFI AYVSNDSLNT KAEELVYETV IKWIKKDPAT RTQYAAELLA VVRLPFIHPS YLLNVVDNEE LIKSSEACRD LVNEAKRYHM LPHARQEMQT PRTRPRLSAG VAEVIVLVGG RQMVGMTQRS LVAVTCWNPQ NNKWYPLASL PFYDREFFSV VSAGDNIYLS GGMESGVTLA DVWCYMSLLD NWNLVSRMTV PRCRHNSLVY DGKIYTLGGL GVAGNVDHVE R (353-702 aa encoded by BC015667)
靶标信息
KLHL29 (Kelch-like protein 29), also known as KBTBD9, is a 655 amino acid protein that is related to the Drosophila Kelch protein. Mutations affecting Kelch function result in failure of Kelch to associate with the ring canals and subsequent female sterility. Human KLHL29 contains six kelch repeats and one BTB (POZ) domain. The BTB (Broad-Complex, Tramtrack and Bric a brac) domain, also known as the POZ (Poxvirus and Zinc finger) domain, is an N-terminal homodimerization domain that contains multiple copies of kelch repeats and/or C2H2-type zinc fingers. Proteins that contain BTB domains are thought to be involved in transcriptional regulation via control of chromatin structure and function. KLHL29 exists as two alternatively spliced isoforms which are encoded by a gene that maps to human chromosome 2p24.1.
仅用于科研。不用于诊断过程。未经明确授权不得转售。
篇参考文献 (0)
生物信息学
蛋白别名: kelch repeat and BTB (POZ) domain containing 9; Kelch repeat and BTB domain-containing protein 9; kelch-like 29; Kelch-like protein 29
基因别名: A230106N14Rik; Gm68; KBTBD9; KIAA1921; KLHL29; mKIAA1921
UniProt ID: (Human) Q96CT2, (Mouse) Q80T74
Entrez Gene ID: (Human) 114818, (Mouse) 208439, (Rat) 298867